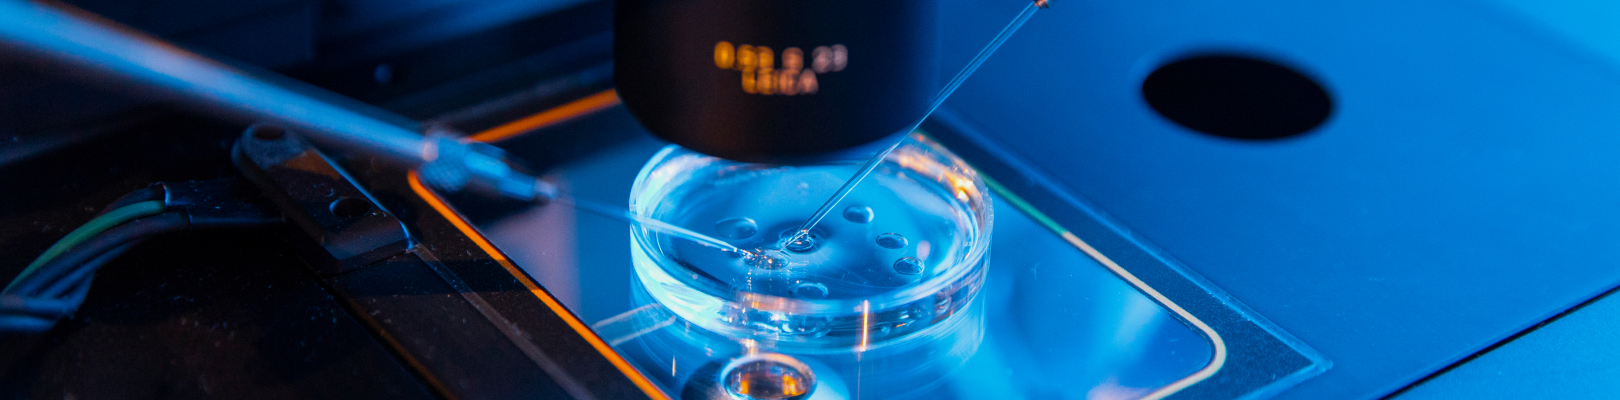

TECHNOLOGY
APMV Vector Platform
KHAV produces recombinant vaccine quickly and safely using the APMV Vector Platform
APMV Vector Platform?
The APMV vector platform serves as a next-generation vaccine platform for emerging animal and human infectious diseases while also being utilized as a next-generation anticancer agent using its inherent oncolytic properties.
- 01. Virus Vector Vaccine : The genetic information of a target antigen is inserted into a non-pathogenic viral vector to produce a recombinant virus that expresses the target antigen.
- 02. Oncolytic Virus : It demonstrates anticancer effects by proliferating and lysing in cancer cells, and activating the anticancer immune system.
APMV Vector Platform
APMV is divided by 22 serotypes, and this diversity can be utilized as a strategy to circumvent the limitations of virus vectors, such as immune responses during repeated administration.
APMV Vector Platform Strength
-
01
Rapidity
 The rapid development of recombinant viruses is possible through the Plug&Play method, which allows for changes in the genetic information of the target protein.
The rapid development of recombinant viruses is possible through the Plug&Play method, which allows for changes in the genetic information of the target protein. -
02
Safety
 Historically, it has been proven safe in birds as it is based on the live attenuated vaccine (Newcastle disease virus), and the development of a safe recombinant virus is also possible in mammals due to limited proliferation capacity and low infection exposure frequency.
Historically, it has been proven safe in birds as it is based on the live attenuated vaccine (Newcastle disease virus), and the development of a safe recombinant virus is also possible in mammals due to limited proliferation capacity and low infection exposure frequency. -
03
Scalability

- By utilizing Sialic Acid, present in the respiratory epithelial cells of various animals, as a receptor during cell infection, it can be developed as a viral vector vaccine that works not only in birds but also in mammals.
- By utilizing the innate oncolytic capabilities of APMV, it is possible to develop anticancer viruses.




